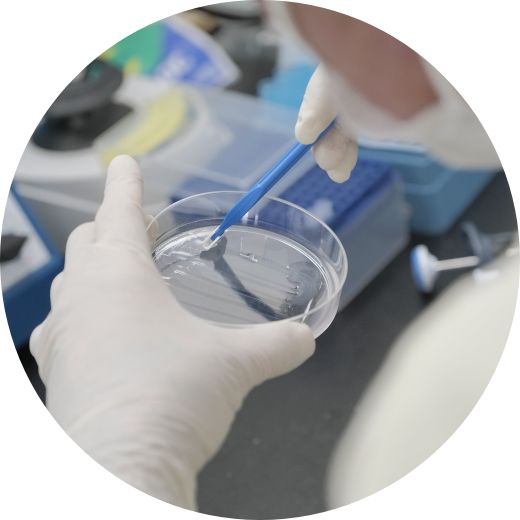

- ホーム >
- 新入局員募集
ご挨拶

学生さんや若い研修医の先生に一番伝えたいことは、シンプルですが「皮膚科は面白い」ということです。私は、大学入学時には皮膚科には何の興味も持っていませんでしたが、恩師である清水宏先生(北大皮膚科・前教授)が「皮膚科は医学のロマンだ」と熱く語る姿に興味を覚え、皮膚科医になりました。皮膚科学は、単に皮疹を見て瞬時に診断するだけの職人芸の世界と思われがちです。しかし、疾患を常に肉眼で観察することができ、さらに、その病変の中で起こっている現象を深く考察することができる臨床科は、皮膚科以外にありません。皮疹がわかるようになるとそのメカニズムを知りたくなり、メカニズムがわかるようになると皮疹がさらにわかるようになりますから、皮膚科学は臨床(マクロ)と研究(ミクロ)がとても合理的に噛み合っている学問であると言えます。教室員には、臨床にもサイエンスにも長けた、「自分の言葉で病気を語ることができる」皮膚科医になってほしいと強く願っています。同時に、臨床の現場では、患者さんの心の痛みがわかる人間性がとても大切です。次世代を担う、バランスのとれた皮膚科医が、筑波大学皮膚科からひとりでも多く育ってくれることを楽しみにしています。当科には出身大学の壁はありませんし、実力勝負ですから、夢を持った若手の先生の参加を心よりお待ちしております。
筑波大学には炎症性疾患から腫瘍まで、あらゆる症例が集まります。
専門医資格の取得に必要な症例を豊富に経験できます。
特徴
当院では、基本的に皮膚科専攻医1-2年目、4-5年目、指導医の3人チームで診療にあたります。人口300万人を擁する茨城県最大の大学病院であるため、最後の砦としてあらゆる症例が集まります。茨城県全域に関連病院も豊富にあり、各病院でかけがえのない経験を積むことができます。これは地方都市ならではの強みです。

教育体制
皮膚科専門医取得には5年間の研修が必要になります。最初の1-2年は筑波大学病院で研修し、入院診療を中心に学ぶこととなります。残り3-4年は関連病院や大学病院で研修します。大学病院にも関連病院にも豊富な症例と教育熱心な指導医がそろっており、専門医取得に必要な症例経験や学会発表、論文指導に事欠くことは一切ありません。大学には各種専門外来もそろっており、集中的に学びたい分野がある場合にも十分な環境を提供できます。

進路
指導医や開業を目指して皮膚科診療を広く学んだり、興味のある専門分野をどこまでも深めたり、後期研修中に大学院へ進学して研究したりすることができます。希望する先生には、国内留学や海外留学も積極的に支援しています。また、育児をしながら働きたい先生には時短勤務枠も用意しています。人によって、働き方は様々です。一人ひとりの価値観と生き方を最大限に尊重する教室でありたいと思っています。
専攻医の
週間スケジュール
| 皮膚科 1-2年目 | 皮膚科 3-5年目 | |||
|---|---|---|---|---|
| チームで病棟診療を中心に研修 |
病棟診療をオーベンとして指導しつつ 外来診療(初診・ 再診・専門)を 中心に研修 |
|||
| AM | PM | AM | PM | |
| 月 | 手術 | 病棟 | 手術 | 病棟 |
| 火 | 病棟 | 病理 カンファ |
外来 | 外勤 |
| 水 | 外勤 | 病棟 | 外来 | 外勤 |
| 木 | 病棟 | 教授回診・カンファレンス | 病棟 | 教授回診・カンファレンス |
| 金 | 手術 | 病棟 | 手術 | 病棟 |
専門外来
様々な専門外来で研修ができます。


魚鱗癬






在籍医の声

①筑波大皮膚科を選んだ理由
初期研修で筑波大学と水戸協同病院の皮膚科で働いた際に、先生方が熱心に指導してくださったことから、確立した指導体制が整っていることを実感して入局しました。筑波大学皮膚科では、専門医取得までの期間に様々な関連病院で研修ができ、知識が豊富な指導医のもとで経験を積むことができます。
②入局してみて
実際に病棟や外来業務で分からないことは上級医にいつでも相談できます。カンファレンスでは、自分が担当した症例のフィードバックがあり、病理検討会もあるため、幅広く勉強できる環境が整っています。さらに、学会発表や論文作成では、指導医が一から教えてくれるため、困ったことはありません。
③メッセージ
働く場所を決めるにあたり雰囲気を知ることは大切なので、いつでも、気軽に見学に来てください。

①筑波大皮膚科を選んだ理由
私は皮膚科と内科系の診療科と悩んでいましたが、最終的には手技が多いことや多様な働き方ができるところに惹かれ、皮膚科を選びました。筑波大皮膚科には例年、様々な大学から4人以上入局することが多く、同期に恵まれた研修生活ができるところも魅力的でした。
②入局してみて
腫瘍やアレルギー、様々な炎症性疾患など、あらゆる疾患について診断から治療まで幅広く経験できています。また、レジデントの先輩や指導医の先生方はみな優しく教育熱心でもあります。基本的なことから相談や質問をして、レクチャーを受けたり一緒に調べたりと、学ぶことの多い日々です。大学病院ならではの忙しさを感じるときもありますが、教室の方針としてきちんと休暇をとることも重視されており、実際きちんと休めています。(有給は全消化推奨です!)
③メッセージ
成長を目指しながらも「生活」が確保できるところも筑波大の良さだと感じます。趣味や出産・育児などのプライベートの希望も実現しつつ、皮膚科医として地域に貢献したい、という先生には最高の環境だと思います。

①筑波大皮膚科を選んだ理由
皮膚科は、医師側も患者さん側も治療の手ごたえを感じて共有できることが診療科の魅力です。その中でも、命にかかわることの多い皮膚悪性腫瘍の治療に魅力を感じ、入局を決めました。筑波大学では皮膚悪性腫瘍に力を入れてきた歴史があり、県内最後の砦として数多くの症例が集まることから充実した研修ができると思い、入局しました。
②入局してみて
茨城県内全域に関連病院があり、大学病院では重症症例、市中病院ではCommon diseaseを中心に経験しました。さらに、国立がん研究センター中央病院で皮膚悪性腫瘍に特化した研修を2年間行うことができました。自分で経験し、できることが増える度に学ぶことが楽しくなります。皮膚科は外来が基本ですが、手術の執刀や内科管理も主体的に行うため、研修終了時には偏りなく皮膚科診療を行えるようになると思います。また手術に少しでも興味があれば、当教室は最高の環境であると自信をもって言えます。
③メッセージ
どの診療科を選択したとしても、思い描いた通りの研修生活を送ることは難しいと思います。しかし皮膚科では幅広い疾患を扱うため、必ず自分に合った道が見つかるはずですし、見つけられるように全力でサポートいたします。当教室は楽しくて穏やかな先生ばかりなので、人間的なストレスもなく働くことができると思います。ぜひ一緒に働きましょう!
女性医師・
子育て支援
「仕事をしっかりやりつつ、出産・育児もきちんとやりたい!」と思っている方にとって、
筑波大学皮膚科はgood choiceです!

そもそも皮膚科の診療は、外来診療の占めるウェイトが高いため、「勤務時間がフルタイムでないから・・・」「当直や夜遅くまでの勤務ができないから・・・」という理由で実施できない診療技術は多くありません。子育てをしながらでも、フルタイム医と同等の技量を診療で発揮できる可能性の高い診療科です。皮膚科は女性が多い診療科であり、近年の日本皮膚科学会の新入会員の7 割が女性です。日本皮膚科学会は「皮膚科の女性医師を考える会」を設けて、
精力的な女性支援を行っています。
そして当教室の取り組みは、他大学と比較してもかなり高い水準にあるものと自負しております。有給休暇、育児休暇を十分に取得するのはもちろんこと、柔軟に時短勤務を行える「女性医師枠」も活用しています。「男性の」産休・育休取得も強力に推奨しており、誰もが仕事と育児の両立ができるような環境を作り続けています。
つくばの街の魅力
つくばの魅力の一つは、何といっても都内までのアクセスのよさです。 都内の主要駅である、「秋葉原」、「北千住」まで乗り換えなしでそれぞれ最短45分、34分で行くことができます。東京へのアクセスが良好なので、仕事もプライベートも充実することでしょう。




